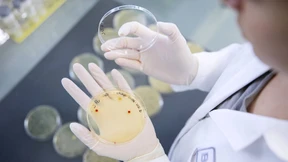
Brain-Biotech gliedert Genscheren-Forschung aus

Keine Angst vor der Genschere
Es ist höchste Zeit, dass die Bundesregierung die ideologischen Scheuklappen bei der grünen Gentechnik ablegt. Denn die Wissenschaft spricht eine deutliche Sprache.

Es ist höchste Zeit, dass die Bundesregierung die ideologischen Scheuklappen bei der grünen Gentechnik ablegt. Denn die Wissenschaft spricht eine deutliche Sprache.

Peter Welters will Gentechnik für die Landwirtschaft erschwinglich machen. Seit 25 Jahren verhindern das Gesetze. Kommt jetzt seine große Chance?

Die Europäische Kommission hat Vorschläge gemacht für den Umgang mit Gentechnik. Damit ist der Erfolg zum Greifen nah, die Ziele im Klimaschutz zu erreichen und mehr Menschen satt zu machen. Ein Gastbeitrag.

Mit Gentechnik könnte unser Essen gesünder und nachhaltiger werden. Die Wissenschaft feiert die Genschere als Instrument gegen den Welthunger trotz Klimawandels. Aber die Grünen sind aus Prinzip dagegen.

Emmanuelle Charpentier, die gefeierte Entdeckerin der Genschere Crispr-Cas, ist seit zehn Jahren eine Galionsfigur – auch für die deutsche Forschung. Auf der Nobelpreiträgertagung am Bodensee hat sie eine bittere Bilanz gezogen.

Die EU-Kommission hat Pläne zur Lockerung des Gentechnikrechts vorgelegt. Die Hoffnung: Neue Techniken sollen schneller resiliente Pflanzen hervorbringen. Damit soll sich auch der Pflanzenschutzmitteleinsatz reduzieren.

Die EU will bestimmte genveränderte Pflanzen wie klassische Züchtungen behandeln. Was Agrarkonzerne und Forscher freut, sorgt in der Biobranche für Unmut.

Der Wissenschaft wächst in der krisengeplagten Welt eine neue Aufgabe zu. Der neue Präsident der Max-Planck-Gesellschaft, Patrick Cramer, sagt, wie er sie lösen will.

Eine schonende Alternative zur Magenverkleinerung: Diese Geschäftsidee hat beim Science4Life-Wettbewerb den ersten Platz erobert.

Der Bauernverbandspräsident Joachim Rukwied erklärt, warum Lebensmittel teuer bleiben, was die Ampelkoalition in seinen Augen versäumt – und ob die Zukunft im Laborfleisch oder im klassischen Schnitzel liegt.

Wie geht es dem Getreide? Was hilft gegen die Trockenheit? Wann verdrängt Photovoltaik den Weizen vom Feld? Ein Gespräch mit dem Landwirt Klaus Münchhoff.

Für Befürworter ist die Geneditierung von Pflanzen die Chance, mit dem Klimawandel mitzuhalten. Die Gegner sehen darin Gentechnik durch die Hintertür. Die EU will die Zulassung nun vereinfachen.

Auf die klassische Gentechnik folgt die Genomeditierung. Und in der EU reifen Pläne, manche Pflanze nicht mehr als Gentechnisch Veränderten Organismus zu bezeichnen. In Deutschland bleibt Skepsis.

Genomeditieren kann helfen, Klima und Umweltprobleme zu lösen. Genforscher Holger Puchta erklärt, wie sicher die neue Technik ist.

Gentechnisch veränderter Reis enthält mehr Provitamin-A und soll Menschen vor Krankheiten bewahren. Ein Experte erklärt, warum er nun nicht mehr gepflanzt werden darf.

Ohne den Einsatz neuer genomischer Techniken wird die Landwirtschaft dem Klimawandel nicht standhalten. Das haben fast alle Staaten der Welt verstanden. In Deutschland steht die Ampel auf Rot.

In den vergangenen Jahrzehnten stieg die Produktivität in der Nahrungserzeugung um ein Mehrfaches – die ökologischen und tierethischen Kosten blieben lange unbeachtet. Teil 3 der Serie über unsere Ernährungslage.

Die Landwirtschaft schützt sich mit alten und neuen Methoden vor der Sommerdürre. Doch das gelingt nicht ohne Konflikte – etwa bei Gentechnik oder Glyphosat.

Bei aller berechtigten Kritik: Der Standort Deutschland ist immer noch innovativ, findet der Bayer-Aufsichtsratschef und warnt vor einem destruktiven Teufelskreis.

Milliardäre aus dem Silicon Valley haben mit ihrem Geld dem Altern den Kampf angesagt. In ihrer Anlagewelt gelten ganz besondere Regeln.

Nach dem Skandal um die Gentherapie des chinesischen Forschers He Jiankui beschäftigte sich nun der Humangenomgipfel in London mit dem Fall: Ein Vertreter der chinesischen Wissenschaftsakademie aus Peking soll für Beruhigung sorgen.

Brauchen wir die grüne Gentechnik, um im Klimawandel die Welt zu ernähren? Ein Gespräch mit Forschungsministerin Bettina Stark-Watzinger über den Nutzen der Biotechnologie für die nachhaltige Landwirtschaft.

Vor fünf Jahren sorgte He Jiankui mit genetisch veränderten Kindern weltweit für Empörung. Jetzt forscht er wieder — an einer neuen Gentherapie. Wissenschaftler sind alarmiert.

Ein Mann wurde durch eine Stammzelltransplantation von seiner HIV-Infektion und Leukämie geheilt. Er ist erst der dritte Patient, bei dem dies geglückt ist. Die Methode ist jedoch nur für wenige geeignet.

Der Versuch, das Altern aufzuhalten, ist zur Milliarden-Dollar-Wette geworden. Die Superreichen aus dem Silicon Valley mischen kräftig mit: Sie haben keine Lust, ihre Jugendträume auf die lange Bank zu schieben.

Hitze, Dürre und Nässe lassen Ernten einbrechen. Forscher versuchen, die Knolle resistenter zu machen. Aber gesetzliche Vorgaben erschweren die Pläne.

Als Bundeslandwirtschaftsminister wartet Cem Özdemir bisher vor allem ab – um bloß nicht anzuecken. Die Folge ist eine Landwirtschaftspolitik, die im Ungefähren bleibt.

Europa ist dabei, sich für grüne Gentechnik zu öffnen. Dem Nobelpreisträger Sir Richard Roberts reicht das nicht.

Vor zehn Jahren wurden die ersten Patienten experimentell mit speziellen Immunzellen therapiert. Jetzt werden diese Zellen gegen Autoimmunleiden und Pilzinfektionen eingesetzt.

Der Max-Planck-Forscher Svante Pääbo hat die Paläogenetik im Alleingang gegründet und den Neandertaler nun zum Superhelden der Humangenom-Forschung gemacht.
Der revolutionären Genschere werden Milliardenumsätze zugetraut. Darauf setzt auch das hessische Biotech-Unternehmen Brain. Es wird seine Genscheren-Forschung ausgliedern - und hofft auf Investoren.

Seit vielen Wochen hat es in Baden-Württemberg wenig geregnet. Die Böden sind ausgetrocknet, Bewässern ist verboten. Das führt zu Ernteausfällen – und großen Sorgen bei den Bauern. Zu Besuch auf einem Hof in Kupferzell.

Allerorten ist angesichts des Krieges in der Ukraine von einer „Zeitenwende“ die Rede. Nur Agrarminister Özdemir hält unbeirrt am Koalitionsvertrag fest – trotz dramatischer Folgen für die Welternährung.

Biotechnik reift und forciert den Wettbewerb: Schnitte im Erbgut zeigen anhaltende Wirkung gegen schwere Leberleiden, gleichzeitig verschärft ein amerikanisches Gericht den Crispr-Patentstreit.

Mehr Ökoanbau, mehr Blumenwiesen: Ist das angesichts des drohenden Weizen-Mangels noch der richtige Weg? Die Grünen sagen Ja. Aber es gibt auch andere Stimmen.

Der Agrarwissenschaftler Urs Niggli erklärt als Pionier des Ökoanbaus, warum Lösungen für die Ernährungskrise nicht mehr warten können – und wieso die Genschere dafür benötigt wird.